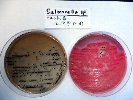

衛生検査
安全と安心の食の提供を目指して
食中毒原因菌の考えられる侵入経路として
食品自体の汚染
食品自体が汚染されていると食中毒が発生します。
自主衛生管理が機能しているかの確認検査としての食品検査を行いましょう。
厨房・器具等の汚染
食品が汚染されていなくても、厨房や器具等が汚染されていれば、食中毒は発生します。
自主衛生管理が機能しているかの確認検査として、ふきとり検査を行いましょう。
工場・厨房の汚染防止のための現状を把握し、対策を立てる基準となります。
二次汚染の防止として
【例】包丁・まな板・水道カラン・取手 etc.
従事者が保菌
食品の汚染・厨房や調理器具の汚染がなくても食品加工従事者が食中毒菌を保菌していると食中毒が発生します。
検便検査は従事者の健康状態を知る検査です。
全員の実施をサポート致します。
大量調理施設衛生管理マニュアル(厚生労働省通知)Ⅲ 衛生管理体制によると、 「責任者は、調理従事者(臨時職員も含む)に定期的な健康診断及び月に1回以上の検便を受けさせること」、 「検便検査には、従来の検査に加え、腸管出血性大腸菌O-157の検査を含めること」、とあります。
食品取扱者の健康・衛生管理のために定期的な検便検査をお勧めします。
 HACCP導入のお手伝い
HACCP導入のお手伝い サルモネラ菌の検査
サルモネラ菌の検査 サルモネラ菌の検査
サルモネラ菌の検査 店舗内や厨房の衛生検査
店舗内や厨房の衛生検査
